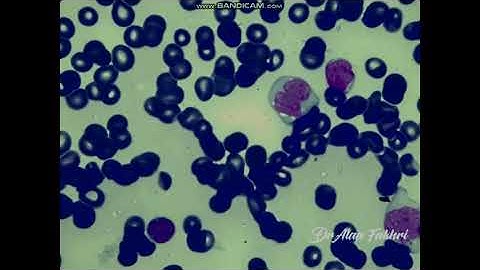
Acute  Myeloid leukemia with monocytic differentiation
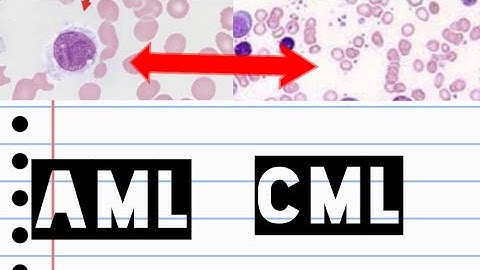
AML & CML | Acute myeloid leukemia | Chronic myeloid leukemia | pathology slide identification |

⬇ DOWNLOAD NOW
Kalau muncul iklan pop-up, tutup lalu klik tombol kembali
Download lagu AML with monocytic differentiation secara gratis hanya untuk keperluan promosi. Dukung artis favorit kamu dengan membeli musik original di iTunes atau platform resmi lainnya.
 MRD assessment in AML with monocytic differentiation: the relevance of the immature fraction
MRD assessment in AML with monocytic differentiation: the relevance of the immature fraction
 Acute Myeloid Leukemia (AML) w/ Monocytic Differentiation (formerly AMML) with Blasts & Promonocytes
Acute Myeloid Leukemia (AML) w/ Monocytic Differentiation (formerly AMML) with Blasts & Promonocytes
 Acute Myeloid Leukemia | Clinical Presentation
Acute Myeloid Leukemia | Clinical Presentation
 ACUTE MONOBLASTIC LEUKEMIA – SYMPTOMS, TREATMENT & SUPPORT
ACUTE MONOBLASTIC LEUKEMIA – SYMPTOMS, TREATMENT & SUPPORT
Acute Myeloid leukemia with monocytic differentiation
Acute Myeloid leukemia with monocytic differentiation
AML & CML | Acute myeloid leukemia | Chronic myeloid leukemia | pathology slide identification |
AML & CML | Acute myeloid leukemia | Chronic myeloid leukemia | pathology slide identification |
 Acute Myeloid Leukemia (AML) - Auer Rods - Myeloperoxidase Positive - Hematology & Oncology Series
Acute Myeloid Leukemia (AML) - Auer Rods - Myeloperoxidase Positive - Hematology & Oncology Series
 ACUTE MYELOID LEUKAEMIA II HEMATOLOGY II ROBBINS 10TH E II PATHOLOGY LECTURES II @DrJIBRANAHMED
ACUTE MYELOID LEUKAEMIA II HEMATOLOGY II ROBBINS 10TH E II PATHOLOGY LECTURES II @DrJIBRANAHMED